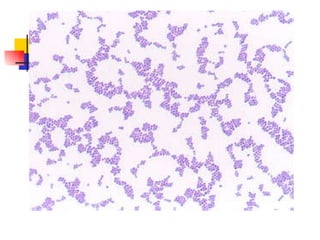
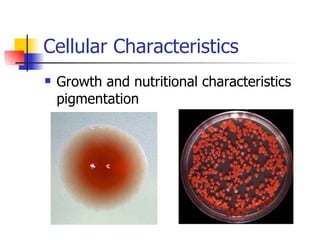
Cellular Characteristics Growth and nutritional characteristics  pigmentation
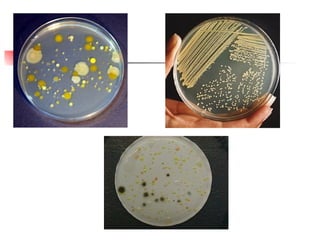
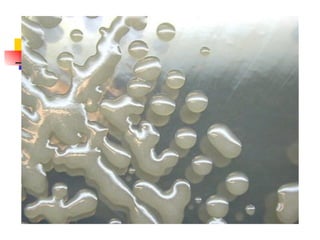

This document provides an overview of microbiology concepts including:
1) It lists common human pathogens and notes that 61% are zoonotic.
2) It discusses the office hours, labs, and lectures for a microbiology course.
3) It summarizes key discoveries and advances in microbiology, infectious disease, and molecular biology from the 18th century to present.